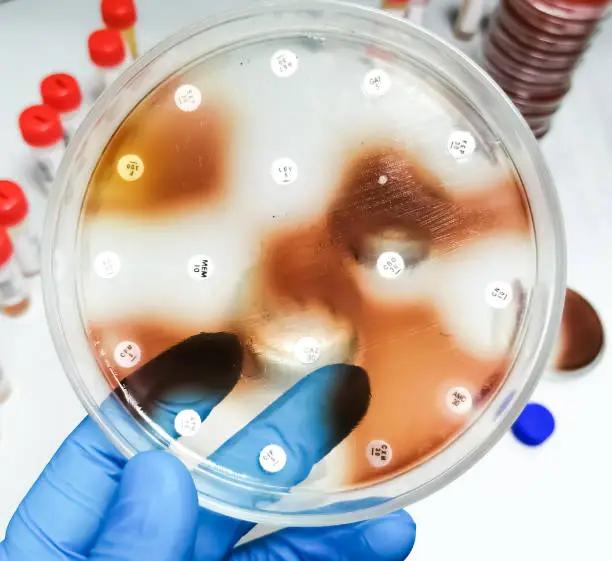

Fungal Infections
Latest News

Petition Urges EPA to Halt Antibiotic and Antifungal Pesticide Use Over Resistance Risks
Latest Videos

Shorts

Podcasts
CME Content
More News

A retrospective study finds no significant difference in treatment failure between patients with obesity and those without.

At ASM Microbe 2025, a Puerto Rico study linked increased fungal spore concentrations to rises in viral respiratory infections, suggesting potential early warning utility.
At ASM Microbe 2025, a cross-sectional study highlighted Burkholderia cepacia dominance, widespread antibiotic resistance, and key risk factors, including invasive device use and patient demographics.

New modeling estimates up to 360,000 symptomatic cases annually, 10 to 18 times higher than reported, with CDC experts calling for expanded testing, reporting, and clinical awareness.

Q&A with Amy Cain discusses cannabidiol and cannabidivarin’s effects on fungal biofilms and drug-resistant strains.

This week, FDA approved Moderna’s improved COVID-19 vaccine mRNA, MAD-ID findings showed omadacycline’s 86% success rate in treating infections in immunocompromised patients, consistent safety in preventing recurrent CDI in patients with comorbidities, and more.

Mycovia Pharmaceuticals is evaluating oteseconazole against the standard of care for treating cryptococcal meningitis.

A published study reveals how an extra gene allows a specific mycetoma-causing fungus to neutralize itraconazole when treating the neglected tropical disease.

Innoviva launches ceftobiprole in the US, shifts in FDA COVID-19 vaccine policy, a surge in fungal infections, and more.

The state reported 3123 cases, a significant jump from 2024's 1011 cases in the same period, with experts citing environmental factors.

SOF/VEL cured 98.9% of 7,027 hepatitis C cases globally, and peptide-decorated liposomes improved antifungal delivery against Candida species, and more

Posaconazole-loaded liposomes decorated with penetratin show up to 1300 times increased efficacy against biofilm formation and reduce fungal burden by 60% in murine models.

A study of an H5N1 strain from a Michigan dairy worker showed airborne transmission in ferrets, bulevirtide achieved sustained virologic response in chronic hepatitis D patients, and more.

Study supports the global need for targeted education to correct misconceptions and improve treatment adherence.

The latest fungal-focused edition of the Centers for Disease Control and Prevention’s journal Emerging Infectious Diseases explores the global spread of antifungal resistance, rising cases of Aspergillus infections, and the detection of Histoplasma.

This week, the CDC ACIP's endorsement of meningococcal, RSV, and chikungunya vaccines, the need to expand automated CD4 testing for improved HIV/AIDS care, and more.

Six hundred thirty-seven cases in England, 4514 US clinical cases in 2023, and only 3 late‑stage antifungal drugs reveal surveillance and treatment gaps.

Jane E. Sykes, BVSc (Hons), PhD, MPH, MBA, discussed how her study revealed a wider geographic distribution of valley fever, highlighting the need for improved human surveillance.

Study uncovers the role of ploidy plasticity in fungal adaptation to fungicides, highlighting risks for human health and agricultural systems.

The organization's reports discuss the small number of newly approved treatments, the limited, late-stage antifungal pipeline, and challenges around diagnostics for this class of infections.

Ashraf S. Ibrahim, PhD, details over 20 years of research on a spore-coating protein and the development of VX-01 to block fungal tissue invasion.

Ashraf S. Ibrahim, PhD, discusses how VX-01 prevents fungal invasion of blood vessels and enhances immune response in immunocompromised patients.

This week, the FDA approved two new drugs, gepotidacin for treating uUTIs in females aged 12 and older, and Tesamorelin F8 for managing excess abdominal fat in adults with HIV-associated lipodystrophy.

This week, recent studies include Mandimycin for resistant fungal infections, fluctuating hospital AMR rates, a 6-month HIV treatment, global challenges in hepatitis testing, and the start of a Lassa fever vaccine trial.

Examined over a 5-year period, the Jackson Health System in Florida reported large volumes of positive cultures for the fungal infection every year and that infection sources expanded over time.









































































































































































































































































































































